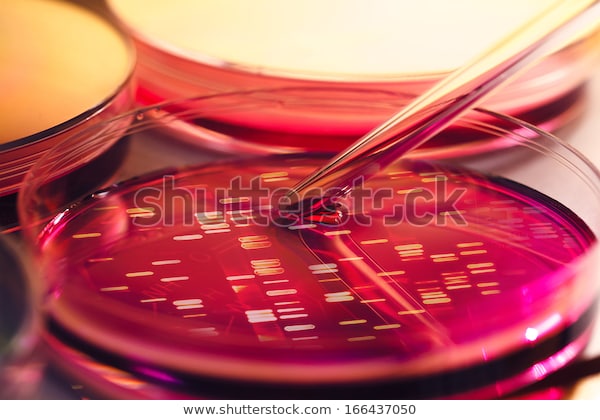
Study image

Testing_Name02



- testing
- Male
- Age 18 - 50
- testing
While participation in a clinical study is voluntary, you may be paid for your time and travel. Compensation is based on the length of the study, the number of overnight stays in our clinic and the number of out-patient visits you attend. You may also be compensated for some procedures depending upon the study. All payments we make for study participation have been approved by an Independent Review Board (IRB). The method and frequency of payment will be described in detail in the Informed Consent Form (ICF).
Even if you don’t qualify for a particular study, you may be able to refer a friend or family member. If approved by an Independent Review Board (IRB), PRA may be able to provide you a referral bonus of up to $300 for each qualified study participant that you refer. To qualify for the payment, the person you refer must:
• Be a first-time volunteer
• Mention your name when applying over the phone
• Fully participate in the study
All payments from PRA Health Sciences must be approved by an IRB before any payment may be made to you. Please contact us for more information.